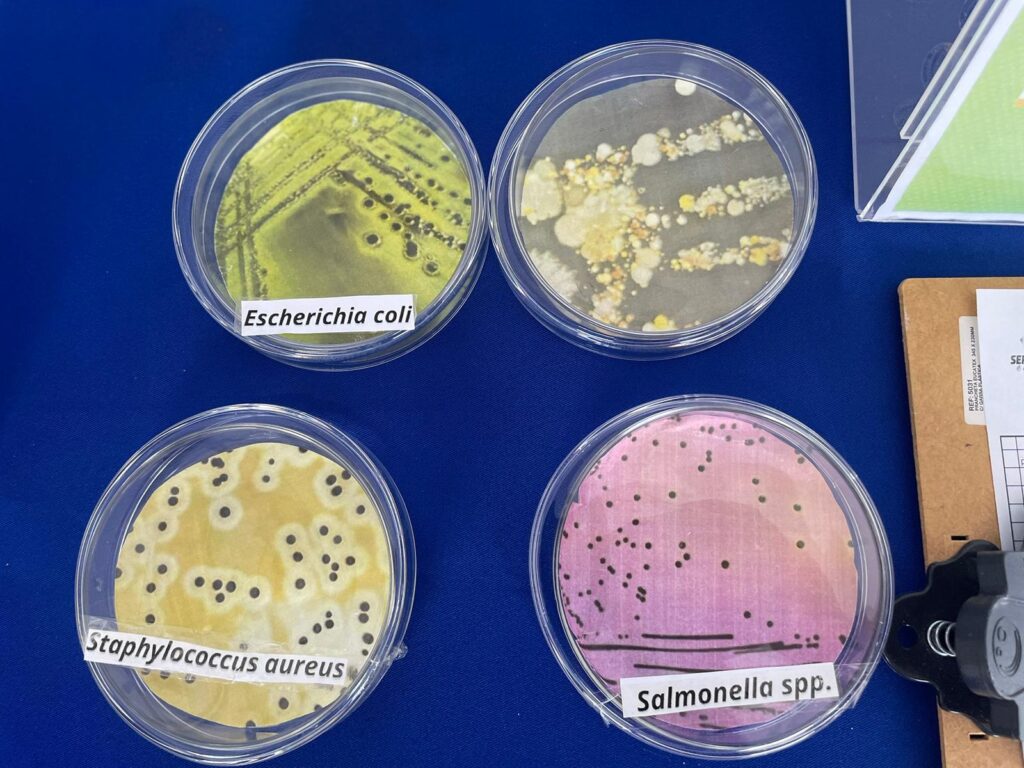

Além do ITPS, SergipeTec e Codise, a Fapitec/SE ofereceu informativos e orientações para a comunidade local
O município de Canindé de São Francisco, localizado no alto sertão sergipano, foi o 32º a receber uma edição do ‘Sergipe é aqui’. A caravana itinerante do Governo do Estado nesta sexta-feira, 9, disponibilizou mais de 160 serviços e ações prestados por secretarias e órgãos da administração pública estadual. A Secretaria de Estado do Desenvolvimento Econômico e da Ciência e Tecnologia (Sedetec) e suas vinculadas estiveram presentes fornecendo orientações para os canindenses.
Em mais uma edição, o Sergipe Parque Tecnológico (SergipeTec) distribuiu mudas de plantas frutíferas e florestais, e apresentou a estrutura do parque. O apicultor Lucas Santos Costa visitou o estande do Sistema Sedetec e foi um dos contemplados com as mudas. “Peguei uma muda de ipê roxo, que vou poder plantar e dar de comida às abelhas. Sempre planto mudas da Mata Atlântica para fazer reflorestamento e ter comida no tempo de escassez. Esse não é o primeiro ‘Sergipe é aqui’ que eu participo, também estive no de Indiaroba. É uma iniciativa muito boa”, contextualizou.
A moradora Joice Freitas também garantiu sua muda e compartilhou sua experiência sobre os serviços oferecidos. “Tenho em casa pés de laranja, tangerina, acerola, goiaba, maracujá, manga, caju, pitomba, abacate… E hoje peguei um pé de araçá aqui no estande. Gosto muito de jardinagem, principalmente de árvores frutíferas, porque a gente usa para o próprio consumo da família. Achei boa essa iniciativa para a população, porque está tendo muito desmatamento e essas plantas já ajudam o meio ambiente”, afirmou.
O Instituto Tecnológico e de Pesquisas do Estado de Sergipe (ITPS) também marcou presença no evento, trazendo um informativo sobre fertilizantes, análise foliar e contagem microbiana, além de realizar coleta e análise de solo. De acordo com Milena Jesus, pesquisadora do Laboratório de Microbiologia do instituto, o ‘Sergipe é aqui’ é uma oportunidade de levar conhecimento qualificado à população.
“Trouxemos quatro variedades para ilustração: fungos, Salmonella, Staphylococcus aureus e Escherichia coli, que são os mais comuns. Trouxemos também panfletos sobre as análises que a gente faz no ITPS, incluindo queijos, leite pasteurizado e diversos alimentos que podemos acabar contaminando na hora do manuseio. Além disso, o instituto também faz análises da água. Assim, queremos estimular um cuidado maior em relação à armazenagem e manuseio, para evitar problemas de consumo”, resumiu.
A Companhia de Desenvolvimento Econômico de Sergipe (Codise), por sua vez, apresentou o Programa Sergipano de Desenvolvimento Industrial (PSDI), detalhando suas vantagens e modalidades de incentivo, além de fazer prospecção de novos negócios, destacando os atrativos econômicos do estado.
“A presença da Sedetec e suas vinculadas no ‘Sergipe é aqui’ é fundamental para aproximar nossos serviços da população sergipana e contribuir diretamente para o desenvolvimento dos municípios atendidos. Já passamos por quase metade dos municípios sergipanos e estamos comprometidos em continuar levando nossos serviços para ainda mais pessoas”, registrou o secretário da Sedetec, Valmor Barbosa.
Atuação
Uma das novidades do Sistema Sedetec na edição foi a presença da Fundação de Apoio à Pesquisa e à Inovação Tecnológica do Estado de Sergipe (Fapitec/SE), que apresentou os editais vigentes e levou aos empreendedores informações sobre o Programa Tecnova III, com edital aberto para submissão de propostas de empresas até 30 de agosto no site: fapitec.se.gov.br.
A participação da Fapitec/SE no ‘Sergipe é aqui’ de Canindé de São Francisco integra as ações da caravana Tecnova, que vem percorrendo o interior sergipano para levar informações a respeito do edital desenvolvido junto à Financiadora de Estudos e Projetos (Finep) do Ministério da Ciência, Tecnologia e Inovação (MCTI). Além de Canindé, o município de Nossa Senhora da Glória recebeu a caravana nesta sexta-feira, 9.